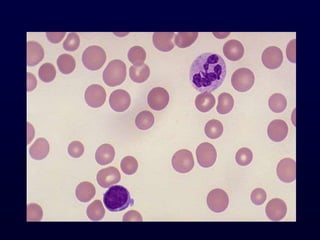

This document provides information on classifying and understanding the pathogenesis of anemia. It discusses definitions of anemia based on hemoglobin levels in adults and children. It also covers evaluating a patient's history for anemia including dietary, medication use, menstrual history, signs and symptoms. The document outlines how to analyze peripheral smear, red blood cell indices, reticulocyte count, and when a bone marrow exam is needed to determine the cause of anemia. It differentiates between macrocytic, microcytic, and normocytic anemias and discusses approach to evaluating each type.